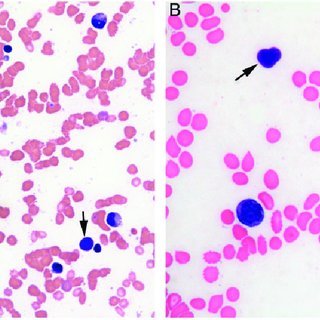

Etiologie - medicamente
HIPP
Hidralazina
Izoniazida
Procaindamida
Penicilamina

LES cu afectare cutanata si renala este caracterizat de prezenta
depozitelor de
complement
+
Ac de tip IgG
+
influx neutrofile + limfocite
Biopsiile altor tesuturi - rar efectuate, dar pot arata
modificari de tip vasculitic ce afecteaza
capilarele
arteriolele
venulele
Sinoviala articulara poate fi
edematoasa
+
contine complexe imune
In infiltratul inflamator pot fi identificati
corpi hematoxilinici = depozite omogene, rotunde, albastre in coloratia cu hematoxilina
rezulta din interactiune Ac anti-nucleari + nuclee celulare

Tablou clinic
mostly
Fatigabilitate
Artralgii
Leziuni cutanate
afectare organe vitale - rara, dar severa cand exista
Manifestari generale
Febra → exacerbari
Fatigabilitate
simptomele NU sunt corelate cu activitatea bolii / severitatea afectarii altor organe
Afectare articulara
cea mai frecventa >90%
simptome gen AR → artralgii simetrice la niv articulatiilor mici
articulatii dureroase, aspect clinic NORMAL
uneori tumefactie discreta la niv tesuturilor moi periarticulare
RAR
deformari cauzate de contractia capsulei articulare si a tendonului
deformare articulara importanta gen cea din AR = artropatia Jaccoud

Necroza avasculara ce intereseaza soldul / genunchiul

complicatie rara a bolii / tratamentului cu CS
Mialgia
50%
miozita adevarata → <5%
miozita importanta → poate avea BRA complexa + suprapunere (overlap) de polimiozita + LES
Tegumentul e afectat in
85% cazuri
Caracteristic LES
eritemul dispus in fluture la nivelul obrajilor + piramidei nazale

Pot fi intalnite si

PELea PULA
Pigmentari
Eruptii plantare + palmare
Livedo reticularis
Purpura
Urticaria
Leziuni vasculitice degete + periunghial
Alopecie

Fotosensibilitate
40-50%
in special la pacientii cu anticorpi anti-Ro +
Pot fi intalnite si

Livedo reticularis
Eruptii plantare + palmare
Pigmentari
Alopecie
Alopecia cicatriciala poate duce la
pierderea focala ireversibila a parului
Fenomenul Reynaud

comun
poate aparea cu multi ani inaintea altor manifestari clinice
Afectare pulmonara
50%
Cele mai frecvente manifestari pulmonare

Pleurezii recurente
Revarsate pleurale (exudate)
adesea BILATERALE
Pneumonita
Atelectazia
→ unii pacienti pot sa dezvolte si

disfunctie respiratorie restrictiva
asociata cu
⇓ volume pulmonare
ascensionari hemidiafragmatice
= SINDROM DE PLAMAN MICSORAT
poate avea o baza neuromusculara
Rareori apare
(mai frecvent in sindroamele OVERLAP)
fibroza pulmonara

Complicatie rara, dar amenintatoare de viata
hemoragia intrapulmonara + vasculita

Inima este afectata in
25% cazuri
Este frecventa
pericardita
cu mici colectii pericardice detectabile ecocardiografic






